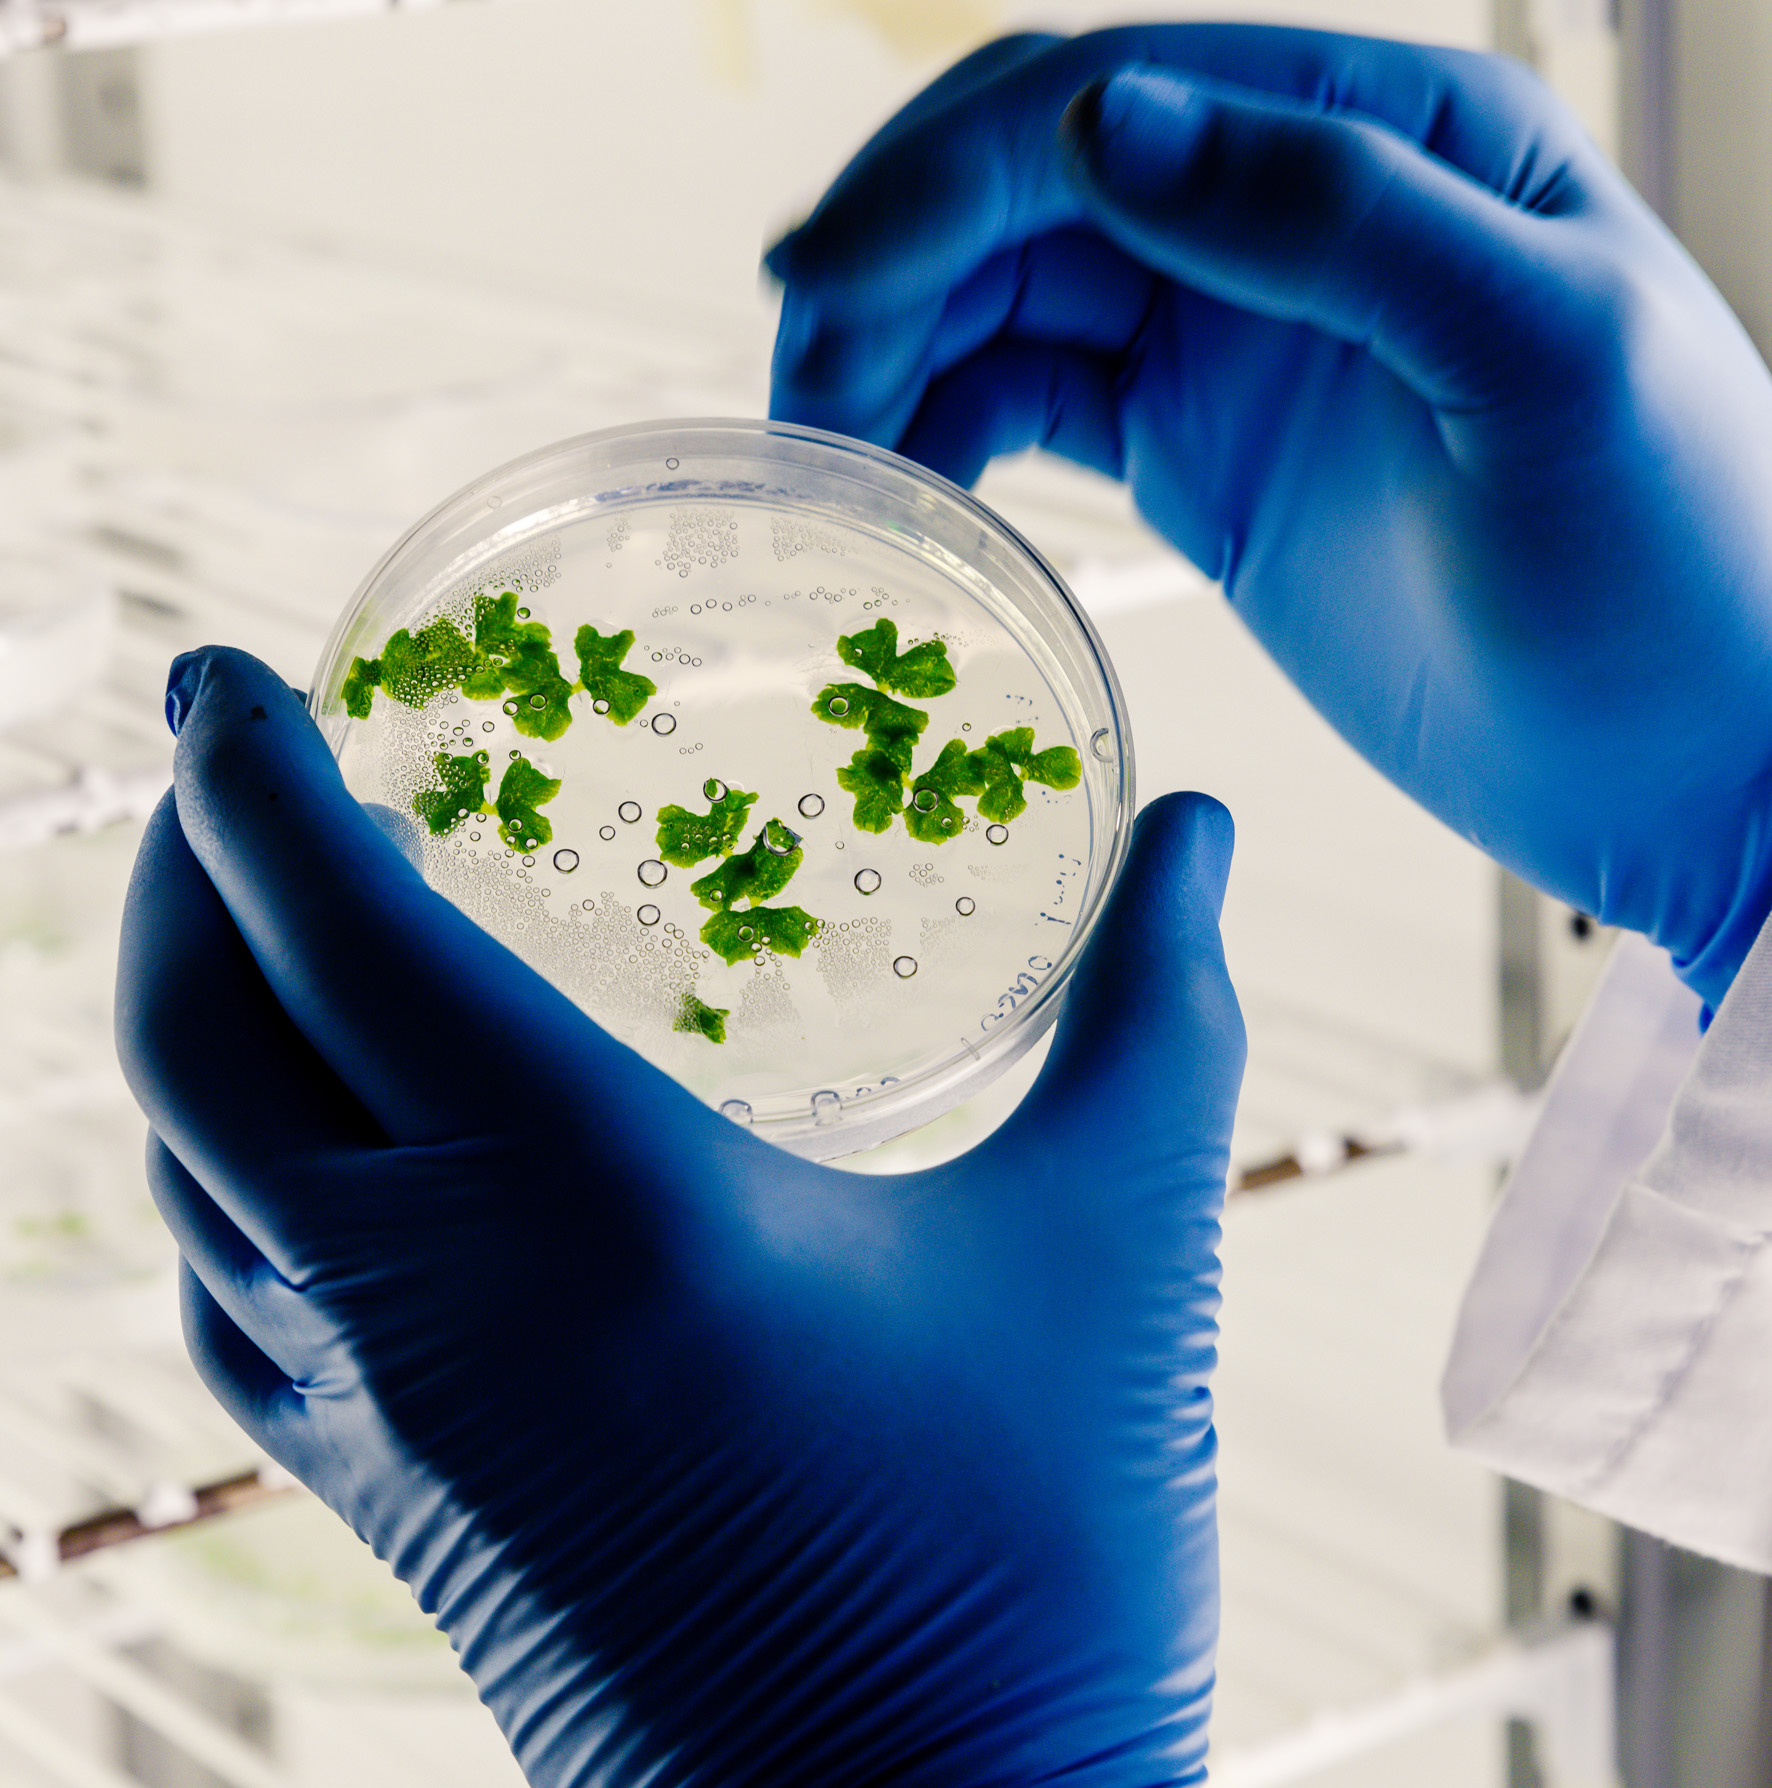

Unlocking the Power of RNA for Next-Generation Diagnostics & Therapeutics
RNA expertise. AI-powered insights. Redefining disease knowledge to improve outcomes.
Value Proposition
Accelerated identification of disease-relevant RNA biomarkers.
Unmasking of new druggable nodes beyond protein-coding genes.
Seamless analytics and visualization for collaborative research.
Specialized expertise in tackling conditions with significant therapy gaps.
At AmarnaBio, we harness the therapeutic and diagnostic potential of RNAs. By integrating advanced machine learning with deep RNA biology, we decode the regulatory networks that drive human disease. Our mission is to deliver novel biomarkers and drug targets, thereby accelerating drug development and improving patient outcomes.
We envision contributing to a world where diseases are identified earlier, treatments are more effective, and healthcare is more targeted.

What Sets Us Apart
Our unique platform uncovers regulatory RNA networks invisible to traditional genomics.
We focus on non-coding and regulatory RNAs that confer tissue specificity and control gene expression.
Our solutions adapt across disease areas, with strengths in neurological and rare disorders.
Team Highlights
Flagship Platform Overview
How It Works
- Data Integration: We aggregate multi-omics datasets to capture the full complexity of RNA regulation.
- AI-Driven Analytics: Machine learning algorithms decode RNA interactomes, revealing novel regulatory networks.
- Biomarker & Target Discovery: We identify, characterize, and validate RNA biomarkers and therapeutic targets with clinical relevance.
- Actionable Insights: Our findings empower partners to operationalize patient classification and accelerate drug development.
Key Capabilities
- Proprietary Biomarker Panels: For patient classification and stratification.
- Target Discovery Solutions: Reveal novel, druggable disease nodes.
- First-in-Class Therapeutic and Diagnostic Opportunities: Explore untapped RNA biomedical space.
- Customizable analytics and visualization for seamless collaboration.
For Biopharma & Clinical Researchers
Strengths
Collaboration Opportunities
We believe in the power of partnerships. AmarnaBio is open to collaborating with academic institutions, biotech firms, and pharmaceutical companies to accelerate research and developmemt.
Contact Form
Ready to explore a partnership or learn more? Fill out the form below, and our team will be in touch




